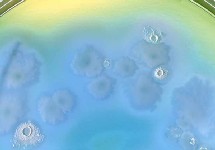

Bacillus Sereus
Científicos de la Universidad de Nebraska han conseguido crear con éxito en laboratorio el primer artefacto de la historia que contiene un microorganismo vivo: una bacteria recubierta de nanopartículas de oro introducida en un chip de silicio que tiene a su vez electrodos también de oro. El trabajo ha sido publicado por la revista Angewandte Chemie.
La bacteria viva se dilata y se contrae a través de los electrodos como respuesta a la humedad, convirtiéndose así en un sensor super-sensitivo. Durante dos días, la bacteria sobrevive en este entorno sin nutrientes, y después sigue funcionando durante más de un mes, realizando la misma función tras su muerte en ese tiempo. De esta forma, el revolucionario dispositivo une al microbio y a la máquina, aprovechando las características de ambos.
¿Qué es un cyborg?
La bacteria incorporada a la máquina es lo que se denomina un cyborg . El término cyborg se formó a partir de las palabras en inglés Cybernetics y Organism (organismo cibernético), y hace alusión a la combinación de biología y mecánica.
En 1960, esta palabra se acuñó para hacer referencia a un ser humano mejorado artificialmente para que pudiera vivir en entornos extraterrestres. Fuera de esas pretensiones, que aún suenan a ciencia ficción, técnicamente sería correcto considerar como cyborg a una persona a la que se hubiese puesto un marcapasos o, simplemente, cualquier mascota que lleve un chip de identificación incorporado en alguna parte de su cuerpo.
Tal como explica la revista Nature, el grupo de químicos de la Universidad de Nebraska, dirigidos por el profesor Ravi Saraf, han desarrollado este artefacto siguiendo el siguiente sistema: en primer lugar tomaron un chip de silicio en el que habían incrustado electrodos de oro. A este chip le añadieron un recubrimiento formado por bacterias del tipo bacillus cereus, común en muchos alimentos. Esta bacteria es un mocroorganismo esporulado (con esporas), lo que le permite sobrevivir durante largos periodos de tiempo en condiciones adversas.
Cambios en la humedad y en el flujo de corriente
Las bacterias se agruparon entonces espontáneamente formando una serie de puentes entre los electrodos. Después, los científicos añadieron al chip una solución de partículas de oro, cada una de las cuales medía alrededor de 30 nanómetros (un nanómetro es la milmillonésima parte de un metro), y por último cubrieron el chip con péptidos (compuesto formado por dos o más aminoácidos), que ayudaron a mantener pegada la bacteria.
El aumento de los niveles de humedad hace que la bacillus cereus se dilate ligeramente, lo que a su vez aumenta la distancia entre las nanopartículas cercanas, en una pequeñísima diferencia, de 0,2 nanómetros. Esta finísima separación hace que sea más difícil para los electrones de las nanopartículas saltar de una de éstas a la siguiente, lo que reduce el flujo de corriente del chip. Por el contrario, una reducción de la humedad del 20% al 0% hace que el flujo de corriente aumente unas 40 veces.
Incluso después de muerta
En el momento de fabricarse el artefacto, la bacteria debe estar viva, con el fin de que no pierda su forma. La bacteria puede vivir unos dos días sin nutrientes, pero sigue reaccionando a los cambios de humedad incluso un mes después de haber sido asimilada.
Según Saraf, con este sistema podrían fabricarse artefactos eléctricos, aprovechando el sistema energético que proporciona la bacteria. Este chip cibernético y biológico es el primer paso para el desarrollo de nuevos aparatos cyborg.
Un sistema similar podría utilizarse también para utilizar organismos vivos como fuente de energía y alimentar así sistemas electrónicos, según los artífices de esta investigación, ya que lo que queda demostrado con esta investigación es que es posible el acoplamiento entre organismos vivos y dispositivos nanométricos.
La bacteria viva se dilata y se contrae a través de los electrodos como respuesta a la humedad, convirtiéndose así en un sensor super-sensitivo. Durante dos días, la bacteria sobrevive en este entorno sin nutrientes, y después sigue funcionando durante más de un mes, realizando la misma función tras su muerte en ese tiempo. De esta forma, el revolucionario dispositivo une al microbio y a la máquina, aprovechando las características de ambos.
¿Qué es un cyborg?
La bacteria incorporada a la máquina es lo que se denomina un cyborg . El término cyborg se formó a partir de las palabras en inglés Cybernetics y Organism (organismo cibernético), y hace alusión a la combinación de biología y mecánica.
En 1960, esta palabra se acuñó para hacer referencia a un ser humano mejorado artificialmente para que pudiera vivir en entornos extraterrestres. Fuera de esas pretensiones, que aún suenan a ciencia ficción, técnicamente sería correcto considerar como cyborg a una persona a la que se hubiese puesto un marcapasos o, simplemente, cualquier mascota que lleve un chip de identificación incorporado en alguna parte de su cuerpo.
Tal como explica la revista Nature, el grupo de químicos de la Universidad de Nebraska, dirigidos por el profesor Ravi Saraf, han desarrollado este artefacto siguiendo el siguiente sistema: en primer lugar tomaron un chip de silicio en el que habían incrustado electrodos de oro. A este chip le añadieron un recubrimiento formado por bacterias del tipo bacillus cereus, común en muchos alimentos. Esta bacteria es un mocroorganismo esporulado (con esporas), lo que le permite sobrevivir durante largos periodos de tiempo en condiciones adversas.
Cambios en la humedad y en el flujo de corriente
Las bacterias se agruparon entonces espontáneamente formando una serie de puentes entre los electrodos. Después, los científicos añadieron al chip una solución de partículas de oro, cada una de las cuales medía alrededor de 30 nanómetros (un nanómetro es la milmillonésima parte de un metro), y por último cubrieron el chip con péptidos (compuesto formado por dos o más aminoácidos), que ayudaron a mantener pegada la bacteria.
El aumento de los niveles de humedad hace que la bacillus cereus se dilate ligeramente, lo que a su vez aumenta la distancia entre las nanopartículas cercanas, en una pequeñísima diferencia, de 0,2 nanómetros. Esta finísima separación hace que sea más difícil para los electrones de las nanopartículas saltar de una de éstas a la siguiente, lo que reduce el flujo de corriente del chip. Por el contrario, una reducción de la humedad del 20% al 0% hace que el flujo de corriente aumente unas 40 veces.
Incluso después de muerta
En el momento de fabricarse el artefacto, la bacteria debe estar viva, con el fin de que no pierda su forma. La bacteria puede vivir unos dos días sin nutrientes, pero sigue reaccionando a los cambios de humedad incluso un mes después de haber sido asimilada.
Según Saraf, con este sistema podrían fabricarse artefactos eléctricos, aprovechando el sistema energético que proporciona la bacteria. Este chip cibernético y biológico es el primer paso para el desarrollo de nuevos aparatos cyborg.
Un sistema similar podría utilizarse también para utilizar organismos vivos como fuente de energía y alimentar así sistemas electrónicos, según los artífices de esta investigación, ya que lo que queda demostrado con esta investigación es que es posible el acoplamiento entre organismos vivos y dispositivos nanométricos.

 Tendencias Científicas
Tendencias Científicas

 La Inteligencia Artificial puede ver a través del espejo
La Inteligencia Artificial puede ver a través del espejo CIENCIA ON LINE
CIENCIA ON LINE